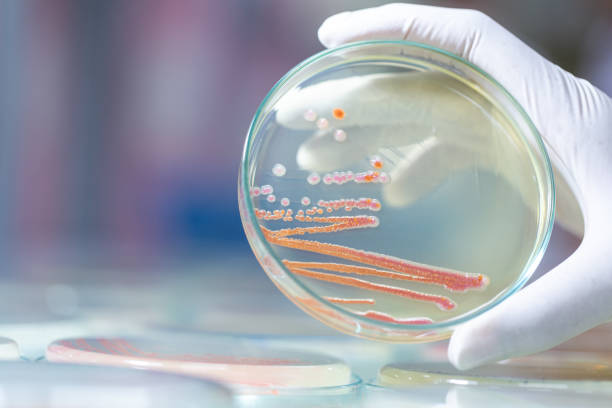
화장실 분홍색 분홍곰팡이 물 때 곰팡이 분홍 청소 얼룩 제거 세균 건강 면역력 호흡기 청소 욕실 변기 얼룩 박테리아 세라티아 마르세센스 락스 표백제

화장실 변기, 세면대, 샤워기, 타일 틈새 등에서 분홍색 또는 붉은색 얼룩, 보신 적 있으신가요?
화장실이나 욕실에 생기는 분홍색 물 때를 일반적으로 분홍 곰팡이라고 많이 부르죠?
많은 사람들이 곰팡이로 오해하지만,
사실 이 분홍 얼룩의 정체는 ‘세라티아 마르세센스(Serratia marcescens)’라는 박테리아(세균)입니다...!!
오늘은
세라티아 마르세센스의 특징과 발생 원인, 건강에 미치는 영향, 효과적인 제거 및 예방 방법까지 알려드리겠습니다! :)

분홍색 얼룩의 오해와 진실
많은 사람들이 화장실 분홍색 얼룩을 곰팡이, 비누 찌꺼기, 물때 등으로 오해하지만, 실은 박테리아인 세라티아 마르세센스가 형성한 ‘생물막’입니다. 생물막은 세균이 스스로를 보호하기 위해 만드는 일종의 끈적한 보호막으로, 일반 세척제로는 완전히 제거하기 어려운 것이 특징입니다.
세라티아 마르세센스(Serratia marcescens)란?
세라티아 마르세센스는 예르시니아과에 속하는 그람 음성 막대균(간균)으로, 자연환경뿐 아니라 병원, 가정의 욕실과 화장실 등 습기가 많은 곳에서 흔히 발견되는 박테리아입니다.
세라티아 마르세센스는 ‘프로디지오신(prodigiosin)’이라는 붉은색 색소를 생성해 분홍색, 붉은색, 때로는 주황빛까지 띠는 생물막을 형성하는 것이 특징입니다.
주요 특징
- 습한 환경에서 번식: 욕실, 변기, 세면대, 샤워기, 타일, 샤워 커튼 등 물기가 남아 있는 습한 곳에서 잘 자랍니다.
- 유기물에 의존: 비누 찌꺼기, 샴푸, 그리고 각질 등 유기물이 풍부한 곳에서 번식력이 더욱 높아집니다.
- 눈에 띄는 색: 붉은색 또는 분홍색의 얼룩, 물때, 생물막 형태로 나타나 쉽게 확인할 수 있습니다.
화장실에서 자주 발생하는 원인과 번식 조건
세라티아 마르세센스가 화장실에서 자주 발견되는 이유는 아래와 같습니다.
- 습도: 욕실과 화장실은 항상 습도가 높게 유지되는 경우가 많아 박테리아가 번식하기에 최적의 환경입니다.
- 온도: 따뜻한 환경이 세균의 성장에 유리하여, 겨울철에 온수 사용 시 더 잘 생깁니다.
- 유기물: 비누 찌꺼기, 샴푸, 각질 등 유기물이 풍부해 세라티아 마르세센스의 영양원이 됩니다.
- 환기 부족: 환기가 잘되지 않는 욕실에서 박테리아 번식이 더욱 활발해집니다.


건강에 미치는 영향
세라티아 마르세센스는 건강한 사람에게는 큰 문제가 되지 않지만, 면역력이 약하거나 극도로 떨어진 사람에게는 심각한 감염을 유발할 수 있습니다.

특히 암 치료 중인 환자, 면역 저하자, 영유아 등은 감염 시 폐렴이나 패혈증 등의 심각한 합병증을 겪을 수도 있으니 청결에 각별한 주의가 필요합니다
효과적인 제거 방법
세라티아 마르세센스는 마찰로 쉽게 닦아낼 수 있지만, 완전히 박멸하지 않으면 습한 환경에서 쉽게 다시 번식합니다.
1. 표백제(락스) 사용
- 락스와 물을 1:10 비율로 희석해 얼룩 부위에 분사합니다.
- 10~15분 불린 후 솔이나 스펀지로 문질러 닦아냅니다.
- 깨끗한 냉수로 충분히 헹궈줍니다.
주의사항
- 락스 사용 시에는 환기를 충분히 하며, 고무장갑·마스크를 착용하여 피부와 호흡기를 보호합니다.
- 락스와 암모니아 등 다른 세정제를 함부로 혼합하여 사용하지 않습니다.
2. 친환경적인 청소법
- 베이킹소다와 식초를 얼룩 부위에 분사합니다.
- 충분히 불린 후 솔이나 스펀지로 얼룩 부위를 문지릅니다.
- 헹궈줄 때 뜨거운 물을 부으면 살균 효과가 더 좋습니다.
3. 정기적인 화장실 청소
- 일주일에 1~2회 이상 욕실, 변기, 세면대, 타일 틈새 등을 위의 방법으로 꼼꼼히 청소합니다.
예방 및 관리법
- 환기: 샤워 후 30분 이상 환풍기 작동 또는 창문 열기
- 건조하게 유지: 샤워 후 바닥, 벽, 변기 주변의 물기 제거를 습관화
- 정기 소독: 표백제, 살균제 등으로 주기적으로 소독
- 유기물 제거: 비누 찌꺼기, 샴푸, 각질 등 박테리아의 먹이가 되는 유기물질을 바로바로 치우기
마무리
화장실의 분홍색 얼룩은 단순한 곰팡이가 아니라 세라티아 마르세센스라는 박테리아의 생물막입니다.
습기와 유기물이 많은 환경에서 잘 번식하며, '면역력이 떨어진 사람'에게는 결막염, 피부 감염, 폐렴, 패혈증 등 건강에 심각한 영향을 미칠 수도 있습니다.
하지만 건강한 사람이라고 해도, 화장실의 분홍색 얼룩은 미관상 좋지 않고 면역력이 떨어졌을 때 질환을 일으킬 수 있다는 걸 생각하면 찜찜하겠죠?
분홍색 얼룩 제거에는 락스와 같은 표백제를 활용한 정기적인 청소와 환기, 건조 유지가 가장 효과적인 예방법입니다. 주기적인 욕실 청소로 건강하고 깨끗한 욕실 환경을 유지하시길 바랍니다. :)
욕실 청소를 깨끗이 하셨다면,
냉수 마찰 한번 해보시는 건 어떤가요?
냉수 마찰의 건강 상 이점과 건강에 도움이 되는 냉수 마찰 시행 방법에 대해
궁금하신 분들은
아랫글을 참고해 주세요 :)
